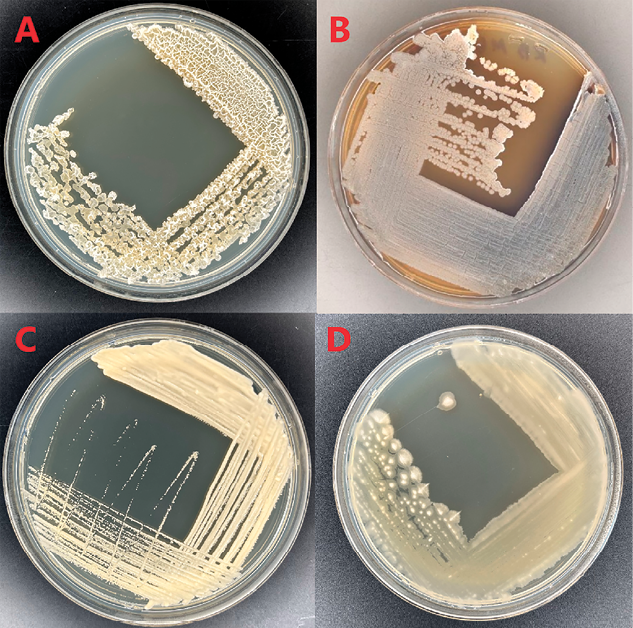

Введение
Паразитирующие на растениях нематоды могут поражать как подземные (корни и корневища), так и надземные (листья, стебли, плоды) части растений. Следствием широкого распространения фитопатогенных нематод является снижение продуктивности растениеводства. Общие потери урожайности возделываемых культур при этом составляют 12–25 % [1]. Наибольший ущерб растениеводству наносят галловые нематоды, обитающие в почве и поражающие корни растений. Это прежде всего нематоды рода Meloidogyne (M. incognita, M. javanica, M. arenaria и др.), злаковые цистообразующие нематоды Heterodera avenae и H. filipjevi, картофельные нематоды Globodera rostochiensis и G. pallida и свекловичная нематода Heterodera schachtii [2].
Для контроля численности фитопаразитических нематод в настоящее время применяют профилактические меры (проведение карантинных мероприятий, использование устойчивых сортов, научно обоснованные схемы севооборота) [3] и химические средства борьбы [4]. Пестициды, применяемые для борьбы с корневыми нематодами, эффективны и удобны в применении. При этом не следует забывать об опасности пестицидов как для сельхозпроизводителей, так и для конечных потребителей продукции растениеводства. Применение пестицидов наносит ущерб окружающей среде, поскольку они уничтожают не только вредителей растений, но и других беспозвоночных.
Дозы пестицидов, применяемые для борьбы с корневыми нематодами, многократно превышают дозы, применяемые для борьбы с другими беспозвоночными вредителями, поскольку очаги паразитирования удалены от поверхности почвы, куда вносятся пестициды [5]. Долгое время основным средством контроля численности корневых нематод являлся препарат TEMIK© на основе карбаматного ингибитора ацетилхолинэстеразы алдикарба. Из-за высокой токсичности алдикарба для человека Всемирная организация здравоохранения запретила использование TEMIK© более чем в ста странах [6]. В настоящее время для борьбы с корневыми нематодами используют фосфорорганический ингибитор ацетилхолинэстеразы фостиазат [7], карбаматный инигибитор ацетилходинэстеразы оксамил и аверсектин, представляющий собой смесь четырех веществ, выделенных из Streptomyces averitilis [8]. К сожалению, высокая токсичность оксамила и фостиазата не только для беспозвоночных, но и для позвоночных животных ограничивает их применение.
Одним из безопасных для человека и окружающей среды методов контроля численности вредителей растений может быть использование микроорганизмов и/или их метаболитов [9, 10].
В лаборатории молекулярно-генетических и микробиологических методов КазНЦ РАН разработаны методы отбора микроорганизмов для биологической защиты растений и принципы формирования консорциума микроорганизмов для оптимизации состояния ризосферы [11]. В этот консорциум входят микроорганизмы, обладающие широким спектром ферментативной активности, способные колонизировать корневую систему и подавлять рост фитопатогенных грибов [12, 13]. Предполагается, что формирование такого консорциума повысит плодородие почвы, урожайность, устойчивость растений к стрессорам и в конечном счете приведет к повышению качества продукции растениеводства. Включение в этот консорциум также и микроорганизмов с нематоцидной или нематостатической активностью позволит снизить негативное влияние галловых нематод на развитие растений и их продуктивность [14].
Удобным модельным организмом для отбора штаммов микроорганизмов, обладающих нематоцидной активностью, является свободноживущая почвенная нематода Caenorhabditis elegans [15]. Эту нематоду удобно выращивать в лаборатории в чашках Петри благодаря маленьким размерам тела (размер взрослой особи всего 1 мм), высокой плодовитости и скорости развития. Проведение экспериментов с C. elegans не требует специальных средств защиты для исследователя, поскольку эта нематода неспособна размножаться при температуре тела человека [16]. C. elegans успешно используется для изучения действия интактных микроорганизмов и супернатантов бактерий на организмы нематод [17].
Целью настоящей работы стало изучение действия бактериальных культур и их супернатантов, содержащих вторичные метаболиты, на разные стадии жизненного цикла почвенной нематоды Caenorhabditis elegans.
Материалы и методы исследования
Выделение и идентификация микроорганизмов
Бактериальные изоляты выделены из ризосферы озимой пшеницы. Отбор образцов проводили на территории Республики Татарстан в окрестностях с. Большие Кабаны 55°62’13.62» с.ш. 49°32’68.39» в.д. на полевых площадях ТатНИИСХ ФИЦ КазНЦ РАН в период с июня по сентябрь 2022 г.
Образцы почвы, корни и надземные части растений собирали в стерильные пробирки. В лаборатории с образцов делали смывы фосфатно-солевым буфером в соотношении 1:9. После перемешивания смывов в течение одной минуты их высевали на неселективную среду Кing В (10 г/л пептона, 10 г/л глицерина, 18 г/л микробиологического агара, 12/5 мМ сульфата магния, 8,6 мМ фосфата калия двузамещенного) с добавлением 32 мкг/мл нистатина и инкубировали в течение суток при температуре 30 °C.
Для идентификации образцов использовался метод молекулярно-генетического анализа по последовательности гена 16S рРНК. Геномная ДНК из каждого изолята была выделена с использованием метода фенол-хлороформной экстракции [18]. ПЦР-амплификацию проводили в соответствии с методикой [19]. Амплифицированный фрагмент очищали от 1,2 % гель-агарозы с помощью набора Cleanup Mini (Evrogen, Москва, Россия). Полученный фрагмент ДНК отправляли в компанию Evrogen для секвенирования. Полученную хроматограмму последовательности 16S рРНК подвергали сравнительному анализу в сервисе NCBI Blast для идентификации.
Определение ферментативных активностей проводили в соответствии с методикой, описанной в работе [11].
Приготовление бактериальной суспензии и получение супернатантов
Для получения бактериальной суспензии единичную колонию изолята асептически переносили в стерильную жидкую питательную среду King B и культивировали на шейкере-инкубаторе при 30 °C и 180 rpm в течение 14 ч. Измерение оптической плотности культур перед нанесением проводили на спектрофотометре Feyond-a400 (Allsheng, Китай) при длине волны λ = 600 нм. Для получения оптической плотности конечной культуры (ОП600 = 0,1) суспензию клеток разводили стерильной питательной средой.
Супернатанты отделяли от основной массы бактерий центрифугированием бактериальной суспензии в течение 10 мин (4000 об/мин, 15 °C). Оставшиеся после центрифугирования клетки удаляли фильтрацией через нитроцеллюлозные фильтры с диаметром пор 0,22 мкм (Sartorius, Германия).
Линии C. elegans и их выращивание
Эксперименты проводили с двумя линиями C. elegans линией дикого типа N2 и мутантной линией DA1316 (avr-14(ad1305) I; avr-15(vu227) glc-1(pk54) V), устойчивой к ивермектину. Линии были получены из Caenorhabditis Genetics Center. Нематод выращивали по методике, описанной в работе T. Belov et al. [20].
Оценка токсичности супернатантов бактерий
Токсичность супернатантов оценивали при 22 °С в M9 буфере [20] в экспериментах с молодыми половозрелыми нематодами, синхронизированными по возрасту [21]. Нематод, отмытых от среды выращивания, бактерий и экзометаболитов, помещали в стеклянные центрифужные пробирки объемом 10 мл (50 особей в одну пробирку), куда добавляли M9 буфер и супернатанты бактерий (конечный объем 1 мл). Негативным контролем служил M9 буфер, а позитивным – ивермектин, антигельминтный препарат. Критерием нематоцидной активности супернатантов служила гибель нематод после 24-часовой инкубации с супернатантами. Состояние нематод оценивали визуально, для наблюдения использовали стереоскопический микроскоп SMZ-05. Каждый вариант эксперимента выполняли в четырех повторностях.
Оценка влияния культур бактерий на развитие и рост C. elegans
Для оценки влияния микроорганизмов на рост и развитие C. elegans культуру бактерий высевали на чашки Петри со средой выращивания нематод и культивировали 24 ч при 30 °С. Стерильные яйца нематод линии дикого типа N2, полученные по методу [21], переносили в чашки Петри, засеянные исследуемыми бактериями, и культивировали при 22 °С. Состояние культур нематод оценивали ежедневно в течение 7 дней визуально с использованием микроскопа Olympus CX43 (Китай).
Рис. 1. Морфология микроорганизмов: А – MGMM30, B – MGMM37, C – MGMM57, D – MGMM36 Примечание: на рисунке приведены оригинальные фотографии, сделанные авторами в ходе исследования
Результаты исследования и их обсуждение
Выделение и идентификация микроорганизмов
Для исследования были отобраны четыре штамма: MGMM30, MGMM37, MGMM57 и MGMM36. Морфология изолятов приведена на рис. 1.
Штамм MGMM30, согласно анализу гена 16S рРНК, принадлежит к виду Bacillus velezensis и имеет различные колонии, от круглых до неправильных, различной высоты, а также секретирует ряд экзоферментов: целлюлазу, липазу, протеазу, амилазу.
Штамм MGMM37 охарактеризован как Streptomyces sp. и представляет собой жесткие, кожистые круглые пигментирующие колонии, а также выделяет липазу, протеазу и амилазу.
Колонии штамма MGMM57 круглые, желтоватые, слизистой формы с гладкими краями. Штамм относится к виду Bacillus thuringiensis.
Штамм MGMM36 принадлежит к виду Bacillus subtilis и представляет собой желтоватые колонии с гладкой блестящей поверхностью. Анализ экзоферментов показал наличие целлюлаз, липаз, протеаз и амилаз.
Влияние супернатантов бактерий на выживаемость нематод
Результаты экспериментов по изучению токсического действия супернатантов бактерий на C. elegans показаны в таблице. Супернатанты бактерий Bacillus velezensis MGMM30 и Bacillus subtilis MGMM36 были токсичны для C. elegans линии дикого типа N2. Супернатант Bacillus velezensis MGMM30 в концентрации 1,25 и 2,5 % вызывал гибель 85 и 94 % нематод соответственно. Супернатант Bacillus subtilis MGMM36 вызывал гибель 52 и 81 % C. elegans при концентрации соответственно 1,25 и 2,5 %. Эти супернатанты были токсичными и для нематод устойчивой к ивермектину линии. В концентрации 1,25 % супернатант Bacillus velezensis MGMM30 вызывал гибель 83 % нематод линии DA1316, А супернатант Bacillus subtilis MGMM36 – 24 % C. elegans, устойчивых к ивермектину. Увеличение концентрации супернатантов до 2,5 % приводило к гибели более 90 % нематод линии DA1316 (таблица). Инкубация C. elegans в среде, содержащей 0,6 нг/мл ивермектина, в течение 24 ч приводила к гибели 80 % особей линии дикого типа N2 и всего лишь 9 % нематод мутантной линии DA1316 (таблица).
Действие супернатантов бактерий и ивермектина на линии Caenorhabditis elegans
|
Доля нематод, погибших за 24 ч, % |
||||
|
Концентрация супернатанта, % |
||||
|
1,25 |
2,5 |
1,25 |
2,5 |
|
|
Линия N2 |
Линия DA1316 |
|||
|
MGMM30 |
85±3 |
94±2 |
83±3 |
96±1 |
|
MGMM36 |
52±4 |
81±3 |
24±3 |
93±2 |
|
Ивермектин 0,6 нг/мл |
80±3 |
9±2 |
||
Примечание: составлена авторами на основе полученных данных в ходе исследования.

Рис. 2. Развитие нематод на 1-е и 7-е сутки при инкубации с бактериальными культурами на чашке Петри: А1 – 1-й день после инкубации яиц нематод со штаммом MGMM30, А2 – 7-й день после инкубации со штаммом MGMM30, В1 – 1-й день после инкубации со штаммом MGMM36, В2 – 7-й день после инкубации со штаммом MGMM36, С1 – 1-й день после инкубации со штаммом MGMM37, С2 – 7-й день после инкубации со штаммом MGMM37, D1 – 1-й день после инкубации со штаммом MGMM57, D2 – 7-й день после инкубации со штаммом MGMM57 Примечание: на рисунке приведены оригинальные фотографии, сделанные авторами в ходе исследования
Оценка влияния культур бактерий на развитие и рост нематод
Наблюдение за состоянием нематод, выращиваемых на различных штаммах бактерий, позволило выявить бактерии, на которых нематоды развивались до половозрелого состояния и задержки развития не наблюдалось. Нематоды при этом активно двигались по поверхности колоний микроорганизмов, численность популяции была высокой. Результаты наблюдений приведены на рис. 2.
На Bacillus velezensis MGMM30 нематоды достигали половозрелого состояния, но их численность была невысокой (рис. 2, A1, A2). Штамм Bacillus subtilis MGMM36 не оказывал какого-либо нематодостатического действия. На рис. 2, В1, видно движение нематод на бактериальной культуре, а на рис. 2, В2, видно развитие крупных нематод в большом количестве.
Особый интерес представляют микроорганизмы, на которых развитие нематод начиналось с задержкой, либо происходила гибель организма. Так, после 7 суток инкубации нематод на Streptomyces sp. MGMM37 (рис. 2С1, С2), погибали уже на стадии L1, поэтому на поверхности агара были видны лишь единичные особи, которые не оставляли потомства и погибали к 4-му дню наблюдений. Колонии Bacillus thuringiensis MGMM57 замедляли развитие нематод из яиц (рис. 2D1) и к концу инкубации, на 7-й день, наблюдались только единичные представители.
Действие бактерий на организм C. elegans изучают, выращивая нематод на среде с тестируемыми микроорганизмами в течение двух-трех недель [17]. При этом нематод ежедневно переносят в новые чашки Петри со средой выращивания и бактериями, одновременно подсчитывают число живых и погибших особей. Погрешность результатов такого эксперимента высокая из-за того, что часть нематод может погружаться в толщу агара либо подвергаться лизису под действием экзометаболитов бактерий. Для сокращения продолжительности эксперимента и повышения точности результатов авторы предложили проводить эксперимент в жидкой среде оценивать нематоцидную активность не интактных бактерий, а не содержащие клетки супернатанты. Такой подход позволяет получить результат в течение нескольких суток или даже нескольких часов. В проведенных авторами экспериментах токсичность супернатантов Bacillus velezensis MGMM30 и Bacillus subtilis MGMM36 в концентрации 1,25 и 2,5 % для C. elegans проявлялась уже через 24 ч (таблица).
Борьба с фитопаразитическими нематодами, обитающими в почве, затрудняется наличием у них кутикулы, защищающей тело как от механических повреждений, так и от проникновения в организм веществ из окружающей среды. Основной пищей нематод являются бактерии, и это является предпосылкой использования микроорганизмов для борьбы с фитогельминтами [17]. Токсины, содержащиеся в бактериях, могут оказывать не только острое токсическое действие, приводящее к гибели нематод, но и изменять физиологическое состояние взрослых особей, нарушая их размножение. Поэтому авторы исследовали особенности роста культуры C. elegans при кормлении разными видами бактерий. Результаты, представленные на рис. 2, показывают перспективность такого подхода. В этой работе были выявлены штаммы микроорганизмов (Streptomyces sp. MGMM37 и Bacillus thuringiensis MGMM57), которые вызывали задержку эмбрионального развития C. elegans и гибель личинок без достижения ими половой зрелости.
В качестве позитивного контроля при изучении действия супернатантов бактерий в экспериментах использовали ивермектин. В качестве нематоцидного препарата ивермектин используется с 1980-х гг. Ивермектин связывается с глутамат-зависимыми Cl-каналами (GluCls) [22, 23], вызывая паралич локомоторных мышц и мышц глотки у C. elegans. У паразитических нематод Trichostrongylus colubriformis, B. malayi и H. contortus и некоторых других ивермектин нарушает пищевое поведение [22, 23]. Устойчивость к ивермектину у C. elegans контролируется тремя генами (avr-15, avr-14 и glc-1), которые кодируют α-субъединицы GluCls [22, 23]. Высокая чувствительность C. elegans линии дикого типа N2 к супернатантам бактерий Bacillus subtillis MGMM36 и Bacillus velezensis MGMM30 в концентрации 1,25 и 2,5 %, выявленная авторами, позволяет сделать вывод о том, что эти супернатанты содержат вещества с нематоцидной активностью. Чувствительность к исследованным супернатантам нематод линии DA1316, устойчивой к ивермектину, свидетельствует о том, что они содержат вещества с нематоцидной активностью, механизм действия которых отличается от механизма действия ивермектина.
Выводы
1. В экспериментах с Caenorhabditis elegans линии дикого типа N2 и мутантной линии DA1316, устойчивой к ивермектину, выявлена высокая нематоцидная активность супернатантов бактерий Bacillus velezensis MGMM30 и Bacillus subtillis MGMM36 в концентрации 1,25 и 2,5 %.
2. Лабораторная культура нематоды Caenorhabditis elegans может быть использована для скрининга супернатантов разных штаммов бактерий на нематоцидную активность.
3. Лабораторная культура нематоды Caenorhabditis elegans может быть использована для выявления штаммов бактерий, подавляющих развитие нематод на ранних стадиях. В дальнейшем эти штаммы могут быть использованы для борьбы с фитопатогенными нематодами в открытом грунте, тепличных хозяйствах и при хранении продукции растениеводства.
4. Химический анализ супернатантов и вторичных метаболитов бактерий, подавляющих развитие нематод, может стать основой для разработки средств борьбы с фитопатогенными нематодами.